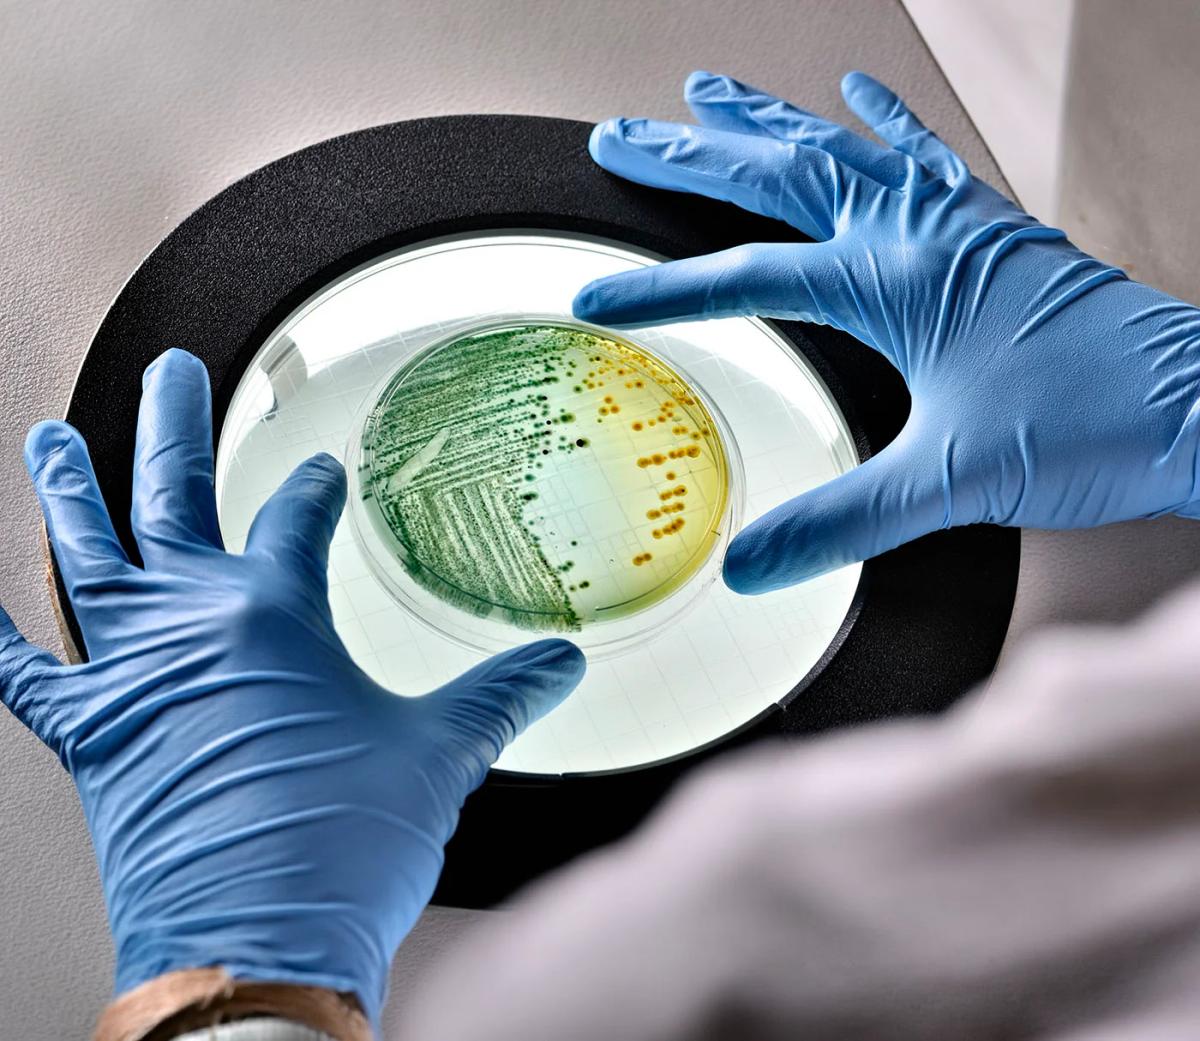
Genomic Mapping of E. Coli Capsules Identifies High-Risk Types for Vaccines

Race to July 2026: Securing Your PV Safe Harbour
Regulators have eliminated the 5 % test for solar projects over 1.5 MW, making the physical‑work test the sole path to safe‑harbour compliance, with a hard deadline of 4 July 2026. Recent observations from Enertis Applus+ across 80 independent‑engineering engagements reveal on‑site issues such as unlabelled components, ERP blind spots, and missing start‑date evidence that threaten the evidentiary chain. The rush to lock in construction dates before the end of 2025 has strained manufacturers and verification providers, amplifying these compliance gaps. Developers who act now can avoid a bottleneck as the July 2026 deadline approaches.

Microsoft Hands Entra ID Users New Option for MFA
Microsoft has made External MFA for Entra ID generally available, leveraging the OpenID Connect standard to let organizations integrate third‑party MFA solutions while retaining Conditional Access controls. The feature appears as an external authentication method that admins can assign to...

Nevermined Unveils Card Delegation for AI Agents, Enabling Autonomous Payments
Nevermined introduced persistent card delegation, letting AI agents hold delegated credit cards and make real‑world payments without human approval. The feature embeds spending limits, duration controls and revocability directly into the infrastructure, mirroring corporate expense policies. By enabling continuous, automated...

Glovo CTO Shiro Theuri Is a Guardian for Benefiting From AI
Glovo’s chief technology officer, Shiro Theuri, is steering the Barcelona‑based delivery platform through a rapid AI integration across its engineering teams. She reports high AI penetration, leading to faster, higher‑quality code while instituting responsible‑AI guardrails and human‑in‑the‑loop reviews. Theuri also...

LG Electronics India Inks 25-Year Solar Deals to Power Two Manufacturing Plants
LG Electronics India has entered 25‑year solar power purchase agreements with Hinduja Renewables Energy and Sunsure Energy to supply its Pune and Greater Noida manufacturing plants. The contracts cover 9.80 MWp and 11 MWp, delivering roughly 32.1 million kWh annually—enough for about 50,000...

Russia Showcases Lys-2 Counter-Drone Interceptor
Russia unveiled the Lys‑2 (Fox‑2) counter‑drone interceptor, a fixed‑wing UAV launched by catapult and capable of autonomous target acquisition in the terminal phase. Open‑source footage shows the system engaging aerial threats without continuous operator input. Reported specifications suggest a 15 km...

First Innovate for Ireland National Centre Launched – ‘Decarb-AI’
Today Ireland unveiled its first Innovate for Ireland national centre, Decarb‑AI, a €5.7 million (≈$6.2 million) initiative partnered with AIB and Research Ireland to accelerate AI‑driven climate resilience. The centre will host 30 international iScholars across three intakes, each pursuing fully funded...

South Korea Targets 2,500 Community Solar Cooperatives by 2030
South Korea’s Ministry of the Interior and Safety launched the Sunlight Income Village program, aiming to create more than 2,500 community‑owned solar cooperatives by 2030. Over 500 villages will be selected this year, with installations ranging from 300 kW to 1 MW...

Orange Leaf Extract Produces Greener Antibacterial Nanoparticles
Researchers have refined a green synthesis route for copper oxide nanoparticles (CuONPs) using water extracts from dried orange (Citrus sinensis) leaves. The optimal protocol—pH 7, 10 g/L copper acetate, and calcination at 300 °C—produces 20‑30 nm particles with strong antibacterial activity against Escherichia coli...

The United Laboratories and Novo Nordisk Report P-II Trial Data on UBT251 in Chinese Patients with Type 2 Diabetes
Novo Nordisk and United Laboratories reported Phase‑II data for the GLP‑1 agonist UBT251 in 211 Chinese patients with type‑2 diabetes. Over 24 weeks, UBT251 achieved a 2.16 % HbA1c reduction, outperforming semaglutide’s 1.77 % and placebo’s 0.66 % from a baseline of 8.12 %....

Belgium: IPP Storm Raises €330 Million, Starts Building 1.2GWh Battery Storage Projects
Storm, a Belgian renewables IPP, secured €330 million (≈US$382 million) project finance to build two large‑scale battery energy storage systems totaling 300 MW/1,200 MWh in Ruien and Langerlo. The Ruien site, a former coal plant, will host a 200 MW/800 MWh system, while Langerlo will host...

Gilead’s Ouro Buy, J&J/Protagonist’s Approval, Aurinia’s Revamp, ACIP Confusion, More
Gilead announced a $2.1 billion acquisition of Ouro Medicines and its T‑cell engager OM336, planning to split the deal with long‑time partner Galapagos. Johnson & Johnson and Protagonist Therapeutics secured FDA approval for Icotyde, an IL‑23 receptor blocker that becomes Protagonist’s...

UK Commits £1 Billion to Accelerate Electric Commercial Vehicle Rollout
The UK government has unveiled a £1 billion (≈$1.25 billion) package to accelerate the adoption of electric delivery vans and trucks. The Zero Emissions Truck and Van scheme will subsidise up to 40 % of vehicle purchase costs, offering grants of up to...

The Man Who Wired Africa
Dare Okoudjou, a Benin‑born telecom engineer, founded MFS Africa—now rebranded as Onafriq—to build the continent’s underlying payments rail. The network interconnects more than 500 million mobile wallets and 200 million bank accounts across 40 African nations, turning a fragmented ecosystem into a...

5 Benefits of Combining Social Data with Search Data
Combining social listening with search analytics lets brands spot intent formation before demand peaks, turning casual conversation into actionable insight. The fusion reveals the full competitive landscape, showing who shapes narratives and who captures demand. It also validates target audiences...

Private Energy Market Deal Unlocks New Solar
UrbanChain has signed the first generation power purchase agreement within its private energy market, securing an 8 MW solar project in Devon that will generate about 9 GWh annually and start operating by summer 2026. A UK financial institution is providing project finance...

Mada Media Offers Investment Opportunity for 21 Digital Unipoles in Dubai
Mada Media has issued tender MM/COM/26-0010 for 21 premium digital unipole billboards along Sheikh Zayed Road in Jebel Ali, Dubai. Licensed out‑of‑home advertisers must submit technical proposals by 16 April 2026 and financial proposals by 23 April 2026. The assets target high‑traffic commuters, offering...

6 Types of AI Content Moderation and How They Work
AI-powered content moderation is reshaping how platforms manage user‑generated material, moving from manual review to a blend of automated and human processes. Six moderation models—pre‑moderation, post‑moderation, reactive, distributed, user‑only, and hybrid—define where and how AI intervenes, from blocking offensive posts...

Six in 10 NHS Consultants Would Favour Online Work
The NHS is rolling out a virtual hospital service, NHS Online, slated to launch in 2027 and target common conditions such as inflammatory bowel disease, menopause and glaucoma. A survey of 303 consultants revealed that 60% would consider working online...
Genomic Mapping of E. Coli Capsules Identifies High-Risk Types for Vaccines
A genomic survey of over 18,000 *Escherichia coli* genomes has mapped 90 capsular K‑loci, revealing that five capsule types (K1, K5, K52, K2, K14) cause more than half of bloodstream and urinary‑tract infections in Europe. The study links these high‑risk...

The UK’s Payments Overhaul Will Be Won or Lost in the Build
The UK is moving from strategic planning to the practical build of its National Payments Vision, launching the Payments Forward Plan to define how the new retail payments infrastructure will be assembled. The article highlights that execution decisions—such as system...

Uber Eats and Starship Expand Robotic Deliveries to New UK City
Uber Eats and Starship Technologies are extending their autonomous food‑delivery robots from Leeds to Sheffield, targeting roughly 50,000 residents. The rollout follows a successful pilot that demonstrated operational reliability and customer acceptance. Industry analysts cite Prysm Global’s study, which estimates...

I Installed ChromeOS on My 9-Year-Old MacBook Air, and It Actually Works
A tech writer revived a 2017 MacBook Air by installing Google’s free ChromeOS Flex, turning a dust‑collector into a responsive secondary laptop. The 128 GB SSD that limited macOS updates proved ample for the lightweight OS, which boots in seconds and...

Social Listening Is Now a Leadership Imperative
Social listening has moved from a marketing tool to a leadership imperative, with executives now monitoring brand reputation and crisis signals in real time. Nicole van Zanten, co‑president of ICUC Social, notes that leaders are using community‑derived insights to guide...

Conclusion of CCS Project Phase as Part of Refocused Strategy for Ocean GeoLoop.
Ocean GeoLoop AS and NorFraKalk AS announced the conclusion of the current development phase for a planned 10,000‑tonne per year carbon capture plant, deciding not to proceed with construction. The decision follows a strategic review emphasizing disciplined capital allocation amid...

Apple Business Launch Brings Maps Ads to Canada
Apple Business launches April 14 with device management and new Apple Maps ads for Canadian businesses. The post Apple Business Launch Brings Maps Ads to Canada appeared first on Retail Insider.

World-First Portable Multi-Pathogen CRISPR Test Seeks to Improve STI Diagnostics
Researchers at Australia’s Peter Doherty Institute have created a portable, CRISPR‑based diagnostic that simultaneously detects syphilis, HSV, chlamydia and gonorrhea in under an hour. The assay also identifies a key antibiotic‑resistance gene in gonorrhea, delivering 97‑100% accuracy compared with laboratory...

Poshmark Unveils Its First Major App Redesign in 15 Years Amid Online Thrifting Boom
Poshmark has launched its first major app redesign in 15 years, revamping the experience for its 165 million buyers and sellers. The update introduces an AI‑driven “For You” home feed, larger portrait‑style product images, and a consolidated seller hub with analytics...

Flipper Zero Pen-Testing Tool Gets an AI-Powered Companion App — Natural Language Interface Allows for Faster, Easier Hacking
Flipper Zero, a compact pen‑testing device, now pairs with V3SP3R, an Android app that leverages OpenRouter AI models to control the hardware via natural language. The app supports text, voice, and image inputs, and can even integrate with Mentra smart...

Virtual Machines, Virtually Everywhere – and with Real Security Gaps
Virtual machines have become ubiquitous in multi‑cloud and hybrid environments, but their ease of provisioning has led to unchecked growth, known as VM sprawl. Organizations often leave idle or over‑privileged VMs running without updates or proper monitoring, creating blind spots...

MSD and Quotient Collaborate on IBD Drug Targets
Merck (MSD) has entered a multi‑year research partnership with Quotient Therapeutics to uncover new drug targets for inflammatory bowel disease using Quotient’s somatic genomics platform. The deal provides Quotient with $20 million upfront and up to $2.2 billion in regulatory, development and...

Volvo Delivers 22 Electric Buses to Transport for NSW
Volvo Bus Australia has delivered 22 BZL electric buses to Transport for NSW, bolstering the state’s Zero Emission Buses Program that targets roughly 1,700 electric units by 2028. The vehicles, built on Volvo’s BZL platform and bodied locally by Volgren,...

CUBE Partners with Microsoft to Automate RegTech at Scale
CUBE has teamed with Microsoft to launch its RegPlatform on Azure, delivering AI‑driven regulatory intelligence that automates compliance for global financial institutions. The integration leverages Microsoft Azure’s secure, globally distributed cloud and data services, enabling real‑time tracking of thousands of...

M&S Rolls Out AI Tools to 11,000 Colleagues Including All Store Managers
Marks & Spencer is rolling out Microsoft 365 Copilot to 11,000 employees, including every store manager, as part of a broader digital transformation. The AI suite will automate routine tasks such as sales insight compilation, meeting‑note summarisation, shift‑roster creation and...

Shane Heraty to Spearhead Cisco’s AI Infrastructure Push in MEA–TRC
Cisco has named Shane Heraty as Vice President and General Manager for its Middle East, Africa, Türkiye, Romania and CIS region, effective May 1. Heraty will drive Cisco’s AI infrastructure, security and workplace modernization strategy across a market of over 1.5 billion...

Elemica Expands AI-Driven Capabilities to Transform Customer Onboarding and Order Orchestration
Elemica announced expanded AI-driven capabilities across its supply‑chain execution platform, adding agentic AI to its Launchpad onboarding service and new self‑service onboarding tools. The technology enables companies to onboard customers and order formats without heavy IT or data‑science involvement, reducing...

Akamai Launches AI Grid Intelligent Orchestration
Akamai announced the first global‑scale implementation of Nvidia’s AI Grid, deploying thousands of RTX PRO 6000 Blackwell Server Edition GPUs across its 4,400‑node edge network. The AI Grid adds an intelligent orchestrator that routes inference requests to the optimal compute tier, slashing...

Nota AI and SiMa.ai Partner on Edge Physical AI
Nota AI and SiMa.ai have formed a strategic partnership to accelerate physical AI at the edge, combining Nota AI's NetsPresso model‑compression SDK with SiMa.ai's high‑performance Modalix MLSoC and Palette SDK. The collaboration will jointly develop and commercialize on‑device AI solutions,...

Design Contract for the Signalling System on the Wessex Line
AtkinsRéalis has secured a £98 million (≈ $124 million) design‑build contract from Network Rail to upgrade signalling and telecommunications on 43 km of the Wessex Line near Portsmouth over the next three years. The project will deploy the firm’s Advanced Signalling Method – the...

Spotify & Monzo Execs Join Unicorn Startup, Spendesk
Spendesk, the AI‑powered spend‑management platform, announced the hiring of Quentin Vigneau as Chief Product Officer and Alan Wright as Chief Technical Officer. The appointments come as the company celebrates its first profitable year and launches a new finance category, Spend...

30% of Open-Web Video Players Shrink After Page Load, Finds Picnic
Picnic’s new PIQ analysis shows that roughly one‑third of open‑web video players shrink after the initial page load, while 15% continue playing after users scroll past and 12% of sites host multiple videos simultaneously. The study highlights a gap between...

Microsoft on Kubernetes: Chaos Will Reign Until We Embrace Shared Operational Philosophy & Interfaces
Microsoft used its KubeCon 2026 appearance to outline a new operational philosophy for Kubernetes, urging a shared approach to reduce fragmentation. Brendan Burns highlighted the chaotic state of AI infrastructure and announced that Dynamic Resource Allocation (DRA) is now generally available,...

Europe Energy Transition Investment Jumps by 19%
European clean‑energy investment reached a record $583 bn in 2025, a 19% year‑on‑year increase and outpacing spending in the United States and China. The surge was driven primarily by electrified transport, offshore wind and power‑grid upgrades, with the EU accounting for...

CoreWeave's CEO Says Being 'Nerdy' Helped It Pivot From Crypto Into a $43 Billion AI Company
CoreWeave pivoted from a crypto‑mining operation to an AI‑focused GPU provider, now valued at $43.6 billion. CEO Michael Intrator credits the company’s "nerdy" background for its deep GPU expertise that enabled a rapid shift after the 2022 ChatGPT surge. Growth is...

Your Essential “Pack” To Select A Digital Analytics Solution: Start From Use Cases, End With Feature Comparison
Selecting a digital analytics vendor often begins with feature comparisons, but Forrester advises starting with business use cases and value objectives. The Forrester Wave™: Digital Analytics Solutions, Q3 2025 offers a technology matrix, while the Digital Analytics Solutions Landscape (Q2 2025) and...

Anthropic Trims Action Approval Loop, Lets Claude Code Make the Call
Anthropic introduced Auto mode for Claude Code, allowing the AI to approve routine file writes and shell commands without constant user confirmation. The feature, initially limited to Team plans and requiring admin enablement, runs on the latest Claude Sonnet 4.6...

Turning Claims Documents Into Decisions
Wisedocs unveiled an AI‑powered decision intelligence platform that automates the entire claims lifecycle, from intake to closure, for insurers, TPAs and legal teams. The solution’s WisePrep, WiseInsights and WiseShare modules classify, deduplicate and analyze documents—handling files over 100,000 pages—while delivering...

How Chemists Turned Bourbon Waste Into Supercapacitors
Chemists at the University of Kentucky have devised a hydrothermal carbonization process that converts bourbon distillery stillage—a waste stream six to ten times larger than the final product—into hard and activated carbon powders. These carbon materials serve as electrodes for...

Explainer: Why AI Is Breaking Enterprise Virtualization
Enterprise AI workloads demand bare‑metal performance, high‑density compute, and ultra‑low latency, exposing the performance penalties of traditional hypervisor architectures. Legacy virtualization adds overhead that becomes a bottleneck at AI scale and complicates management across fragmented toolchains. A licensing shock with...